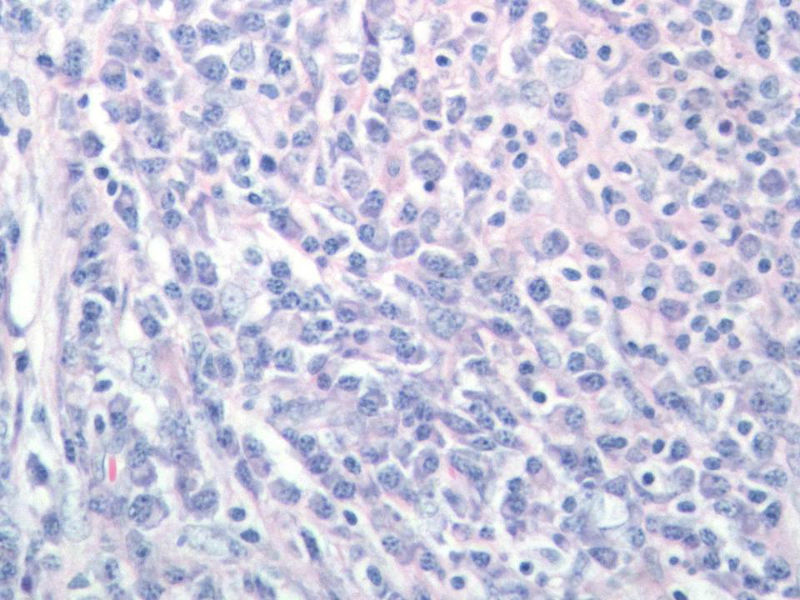
右颌下肿块,新加免疫组化图17 右颌下肿块,新加免疫组化图17

女,56岁,右颌下肿块两月余,检查肿块活动度差,手术切除。肉眼,灰白类圆形肿物,2X2X1厘米。包膜不完整,切面灰白色,质软。

名称:图1
描述:幻灯片1

名称:图2
描述:幻灯片2

名称:图3
描述:幻灯片3

名称:图4
描述:幻灯片4

名称:图5
描述:幻灯片5

名称:图6
描述:幻灯片6

名称:图7
描述:幻灯片7

名称:图8
描述:幻灯片8

名称:图9
描述:幻灯片9

名称:图10
描述:幻灯片10

名称:图11
描述:幻灯片11

名称:图12
描述:幻灯片12

名称:图13
描述:幻灯片13

名称:图14
描述:幻灯片14

名称:图15
描述:幻灯片15

名称:图16
描述:幻灯片16
名称:图17
描述:幻灯片17